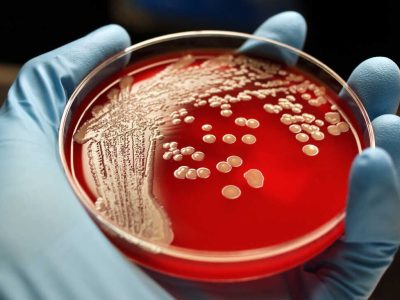
شناسایی یک آنتی‌بیوتیک جدید برای مبارزه با باکتری‌های خطرناک و مقاوم

به گزارش بهروز خبر به نقل از گروه علم و آموزش ایرنا از «سای تک دیلی»، از سالهای پیش این تصور وجود داشته که آنتیبیوتیکها یک درمان معجزهوار برای عفونتهای باکتریایی هستند. اما بسیاری از پاتوژنها در طول زمان تحول یافته و در برابر آنتیییوتیک مقاوم شدهاند و از این رو تلاش برای ساخت داروهای جدید به یک نیاز فوری تبدیل شده است. محققانی از دانشگاه «بازل» (Basel) بخشی از یک تیم بینالمللی بودند که از تحلیل محاسباتی برای برای شناسایی یک آنتیبیوتیک جدید و شناخت حالت عملکرد آن استفاده کردند. این تحقیقات گام مهمی در مسیر ساخت داروهای جدید و نیرومند است.
سازمان جهانی بهداشت (WHO) از شمار فزاینده باکتریهای مقاوم به آنتیبیوتیک به عنوان یک «پاندمی خاموش» یاد میکند. اوضاع وقتی بدتر میشود که بدانیم در دهههای اخیر داروهای جدید زیادی وارد بازار نشده است. حتی الان، امکان درمان مناسب همه عفونتها وجود ندارد و بیماران با خطر برخی لطمات رو به رو هستند.
برای توقف گسترش باکتریهای مقاوم به آنتیبیوتیک به مواد جدید فعال بطور فوری نیاز است. یک کشف مهم به تازگی توسط تیمی به رهبری محققان «دانشگاه شمال شرقی» در بوستون (آمریکا) و پروفسور «سباستین هیلر» از دانشگاه بازل انجام شد. نتایج این تحقیق در نشریه «نیچر میکروبیولوژی» منتشر شده است.
محققان این آنتیبیوتیک جدید با نام «دینوباکتین» (Dynobactin) را از طریق رویکرد غربال محاسباتی کشف کردند. این ترکیب باکتریهای «گرام منفی»/مقاوم به دارو و آنتیبیوتیک ( Gram-negative) را میکُشد که شامل بسیاری از پاتوژنهای مقاوم و خطرناک میشود.
تیم (گروه) هیلر سال گذشته نحوه عملکرد آنتیبیوتیک پپتید تازه کشف شده «داروباکتین» (Darobactin) را شناسایی کرد. دانش به دست آمده وارد فرایند نظارت برای ترکیبات جدید شد. محققان از این حقیقت استفاده کردند که بسیاری از باکتریها برای مبارزه با یکدیگر پپتیدهای آنتیبیوتیک تولید میکنند و این پپتیدها بر خلاف مواد طبیعی، در ژنوم باکتریها کدگذاری میشوند.
محققان میگویند: ژنها برای چنین آنتیبیوتیکهای پپتید یک خصوصیت مشترک دارند. بر اساس این خصوصیت، رایانه بطور سیستماتیک کل ژنوم باکتریهای سازنده چنین پپتیدهایی را غربال میکند و محققان از همین طریق موفق به شناسایی دینوباکتین شدند. این محققان در مطالعه خود نشان دادند که این ترکیب جدید بسیار موثر است. موشهای مبتلا به عفونتهای کُشنده ناشی از باکتریهای مقاوم با دریافت داروی دینوباکتین از عفونت شدید نجات یافتند.
محققان از طریق ترکیب متدهای مختلف قادر به تجزیه و تفکیک (resolve) ساختار و نیز مکانیزم عمل دینوباکتین شدهاند. این پپتید پروتئین غشای باکتریایی BamA را که نقش مهمی در تشکیل و حفظ پوشش (لفاف) باکتریایی محافظ بیرونی دارد، مسدود میکند.
این دانشمندان در عین حال در سطح مولکولی دریافتند که فعل و انفعالات دینوباکتین متفاوت از داروباکتین، با BamA واکنش دارد. از طریق ترکیب خصوصیات خاص شیمیایی این دو، میتوان داروهای بالقوه را تا حد بیشتری ارتقا داد و بهینه سازی کرد.